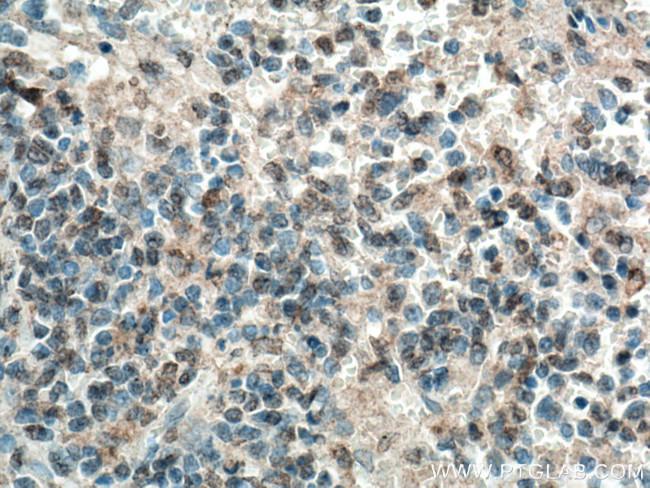
MASTL Antibody in Immunohistochemistry (Paraffin) (IHC (P))

Search
Proteintech
MASTL Polyclonal Antibody
{{$productOrderCtrl.translations['antibody.pdp.commerceCard.promotion.promotions']}}
{{$productOrderCtrl.translations['antibody.pdp.commerceCard.promotion.viewpromo']}}
{{$productOrderCtrl.translations['antibody.pdp.commerceCard.promotion.promocode']}}: {{promo.promoCode}} {{promo.promoTitle}} {{promo.promoDescription}}. {{$productOrderCtrl.translations['antibody.pdp.commerceCard.promotion.learnmore']}}
产品信息
15739-1-AP
种属反应
宿主/亚型
分类
类型
抗原
偶联物
形式
浓度
规格
纯化类型
保存液
内含物
保存条件
运输条件
产品详细信息
Aliquoting is unnecessary for -20°C storage.
靶标信息
MASTL or microtubule associated serine/threonine kinase-like belongs to the MAST family, AGC Ser/Thr protein kinase group. MASTL promotes mitotic progression and cell cycle reentry after DNA damage. Loss of MASTL leads to defects in chromosome condensation, separation, and other aspects of mitotic progression, which is primarily mediated by inhibiting PP2A/B55 delta. Overexpression of MASTL is correlated with cancer progression, poor patient survival, and tumor recurrence in various cancers. Mutations at this locus have been associated with autosomal dominant thrombocytopenia, also known as thrombocytopenia-2. Alternatively spliced transcript variants have been described for this locus.
仅用于科研。不用于诊断过程。未经明确授权不得转售。
生物信息学
蛋白别名: greatwall kinase homolog; greatwall protein kinase; GW; hGWL; MAST-L; Microtubule-associated serine/threonine-protein kinase-like; RP11-85G18.2; Serine/threonine-protein kinase greatwall; unnamed protein product
基因别名: 2700091H24Rik; C88295; GREATWALL; GW; GWL; MAST-L; MASTL; THC2
UniProt ID: (Human) Q96GX5, (Mouse) Q8C0P0
Entrez Gene ID: (Human) 84930, (Mouse) 67121